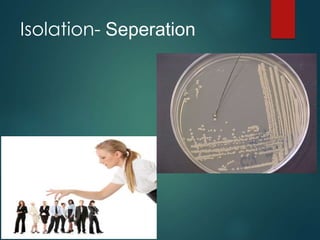
Isolation- Seperation

This document provides an overview of fermentation and bioprocess technology. It begins with definitions of fermentation and discusses the basic requirements for microbial growth. It then covers topics like batch, fed-batch, and continuous fermentation processes. Different types of fermenters and components like spargers and impellers are described. The document discusses strain selection and improvement methods. It also provides examples of industrial fermentation processes like ethanol production and antibiotic production. Finally, it gives an overview of downstream processing techniques used to purify products from fermentation broth, such as centrifugation, filtration, and extraction.